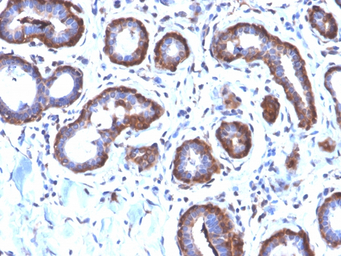
产品细节图片2

相关产品推荐更多 >
万千商家帮你免费找货
0 人在求购买到急需产品
- 详细信息
- 文献和实验
- 技术资料
- 免疫原:
Recombinant human FTL protein fragment (around aa 38-165)
- 亚型:
IgG
- 形态:
Liquid
- 保存条件:
Store as concentrated solution. Centrifuge briefly prior to opening vial. Store at 4ºC.
- 克隆性:
Monoclonal
- 标记物:
Unconjugated
- 适应物种:
Human
- 保质期:
12 months from the shipping date of the product.
- 抗原来源:
Human
- 目录编号:
GTX02641
- 级别:
Primary Antibodies
- 库存:
Available
- 供应商:
GeneTex
- 宿主:
Rabbit
- 应用范围:
WB, IHC-P
- 浓度:
200 μg/ml (Please refer to the vial label for the specific concentration.)
- 靶点:
Ferritin Light Chain
- 抗体英文名:
Ferritin Light Chain antibody [FTL/2338R]
- 抗体名:
Ferritin Light Chain 抗体 [FTL/2338R]
- 规格:
100 μg

WB analysis of HeLa whole cell lysate using GTX02641 Ferritin Light Chain antibody [FTL/2338R].
IHC-P analysis of human breast carcinoma section using GTX02641 Ferritin Light Chain antibody [FTL/2338R].

WB analysis of human kidney tissue lysate using GTX02641 Ferritin Light Chain antibody [FTL/2338R].
风险提示:丁香通仅作为第三方平台,为商家信息发布提供平台空间。用户咨询产品时请注意保护个人信息及财产安全,合理判断,谨慎选购商品,商家和用户对交易行为负责。对于医疗器械类产品,请先查证核实企业经营资质和医疗器械产品注册证情况。
 文献和实验
文献和实验Structure and Properties of Human Immunoglobulin Light-Chain Dimers
Antibodies are multisubunit proteins, but unlike many other multisubunit proteins, it is possible to study structural and functional properties of an antibody subunit free of the others. Thus, antibodies are singular proteins
Analysis of Single Chain Antibody Sequences Using the VBASE2 Fab Analysis Tool
the analysis of multiple rearranged immunoglobulin sequences. In this chapter, we demonstrate the use of the new Fab Analysis – a unique tool that is tailored for the analysis of both heavy and light chain sequences of a given antibody or collection
(two heavy and two light chains) held by interchain disulfide bonds. This is not suitable for expression from DNA vectors, as the individual chains would not assemble in the cytoplasm. Therefore, antibody fragments have been employed in the single chain Fv
 技术资料
技术资料暂无技术资料 索取技术资料







![Angiopoietin 2 antibody [117]](https://img1.dxycdn.com/2022/0328/572/0685436384708700453-14.png!wh200)
![SNRPC antibody [4H12]](https://img1.dxycdn.com/2022/0328/899/8511907998536700453-14.jpg!wh200)
![CD38 antibody [CD38/4247R]](https://img1.dxycdn.com/2022/0328/313/0655167478559700453-14.jpg!wh200)
